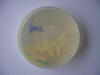

|
|
VISITA Ó INSTITUTO DE INVESTIGACIÓNS MARIÑAS EN BOUZAS NOVEMBRO DE 2006 |
|
O pasado mes de Novembro un grupo de alumnos e profesores de Bioloxía do Instituto asistimos a un taller de patoloxía celular no Instituto de Investigacións Mariñas en Bouzas, dependente do Consello Superior de Investigacións Científicas. |
|
|
Nos laboratorios do Instituto fomos atendidos pola Dra. Beatriz Novoa e o seu equipo que nos enseñaron algunhas das técnicas que utilizan habitualmente no diagnóstico de enfermedades de organismos mariños: PCR, ensaios de fagocitose en hemolinfa, aillamento de microorganimos por sementeira en placa, cultivos celulares, cortes histolóxicos, etc. |
|
| Nas seguintes ligazóns tes información complementaria de algunhas destas técnicas: | |
|
GALERÍA DE FOTOS |
|
|
|
|